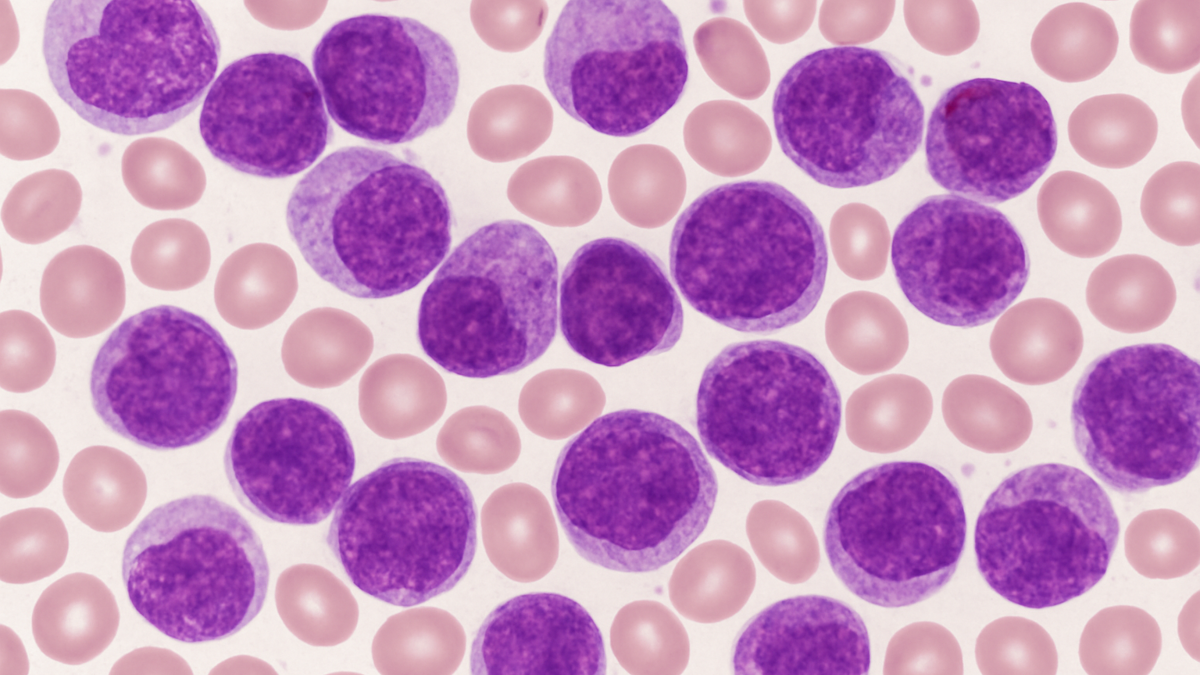

Orum Therapeutics, a public biotechnology company working on degrader-antibody conjugates (DACs), has presented preclinical data for ORM-1153 at the 67th American Society of Hematology (ASH) annual meeting in Orlando, Florida.
ORM-1153 is a novel CD123-targeting DAC designed to deliver Orum’s proprietary GSPT1-degrading payload selectively into cancer cells to achieve targeted protein degradation and antitumour activity in acute myeloid leukaemia (AML) and other CD123-positive haematological malignancies.
“These data highlight ORM-1153 as a differentiated therapeutic candidate designed to address the need for more effective and better-tolerated treatments for acute myeloid leukemia,” said Sung Joo (SJ) Lee, founder and CEO of Orum Therapeutics.
“AML remains one of the most challenging hematologic cancers to treat, with frequent relapse and limited options, particularly for patients with TP53-mutant disease. These data demonstrate the potential of ORM-1153 to achieve potent antitumor activity with a differentiated safety profile, addressing long-standing limitations of current AML therapies and further validating the versatility of our targeted protein degrader approach.”
The preclinical data presented at ASH show that ORM-1153 drives efficient, CD123-dependent internalisation and degradation of GSPT1, resulting in strong and durable antitumour activity in AML models, including TP53-mutant disease. In comparative studies, ORM-1153 demonstrated approximately 1,000-fold higher potency than the unconjugated degrader payload and produced dose-dependent tumour regression in a disseminated AML xenograft model, with complete and durable responses at the highest dose level.
ORM-1153 maintained a favourable tolerability profile and showed minimal effects on normal hematopoietic progenitors in colony-forming assays, suggesting potential for a differentiated therapeutic window compared with current standard-of-care. Together, these findings support ORM-1153 as a promising candidate for the treatment of AML and other CD123-positive hematologic malignancies.
Orum’s Dual-Precision Targeted Protein Degradation (TPD²) approach builds novel targeted protein degraders combined with the precise cell delivery mechanisms of antibodies to generate innovative, first-in-class, cell-selective TPDs for the treatment of cancer and other serious diseases.
Orum has developed new targeted protein degrader payloads to specifically degrade an intracellular target protein within cancer cells via the E3 ubiquitin ligase pathway. Conjugated to antibodies, the payloads are designed to be delivered specifically to target cells and precisely degrade the intracellular target protein of interest.